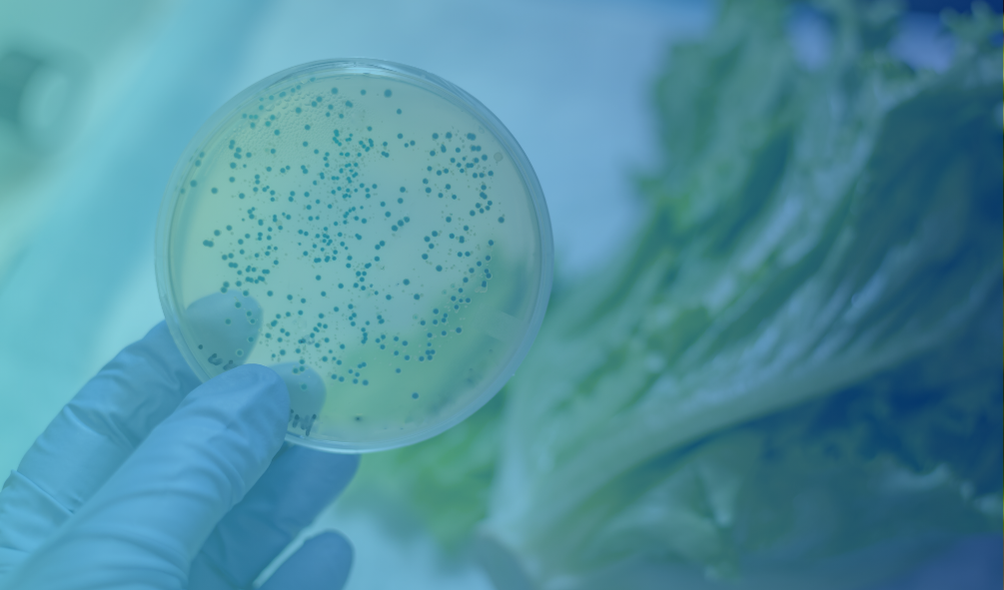

Vreemd voorwerp

Consument treft naalden aan, maar is zelf onvindbaar
Wat als gegevensbescherming jouw onderzoek in de weg staat?

Jouw bedrijf in het vizier van criminelen
Opzettelijke contaminatie, sabotage of identiteitsfraude… Wat nu?

Hoe scoort jouw bedrijf op Food Defense?
Jouw woonplaats beveiligen is een evidentie, maar de beveiliging van de werkplaats komt minder spontaan. Dat bewijst onze praktijkervaring bij voedingsbedrijven.

Een consument reageert niet zoals verwacht, wat nu?
Wat doe je wanneer je wordt geconfronteerd met een onverwachte reactie? Hoe zorg je ervoor dat jouw consumentendienst voorbereid is op zo'n situatie?
Een consument vindt ongedierte in jouw product: wat nu?
Stel je voor: een consument opent nietsvermoedend een van jullie producten en verstijft plots. Aan de binnenkant van de verpakking kruipen kleine insecten. De oorzaak? Een besme...

Hoe een gemiste incidentmelding leidde tot een grote recall
Een consument vindt een stuk plastiek in één van jullie producten. Wat eerst een alleenstaand geval leek te zijn, bleek een teken aan de wand van een groter probleem.